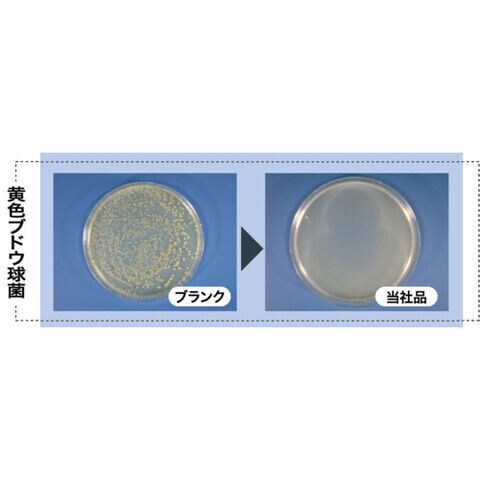

4/26
時点_ポイント最大3倍
Linda 銀バスクリーナープラス アルカリ性 [SA13] SA13 販売単位:1 送料無料
販売価格
6,580
円 (税込)
送料込み
- 出荷目安:
- 店舗へお問い合わせください
たまるdポイント(通常) 59
+キャンペーンポイント(期間・用途限定) 最大2倍
※たまるdポイントはポイント支払を除く商品代金(税抜)の1%です。
※表示倍率は各キャンペーンの適用条件を全て満たした場合の最大倍率です。
各キャンペーンの適用状況によっては、ポイントの進呈数・付与倍率が最大倍率より少なくなる場合がございます。
dカードでお支払ならポイント3倍
各キャンペーンの適用状況によっては、ポイントの進呈数・付与倍率が最大倍率より少なくなる場合がございます。
- 商品情報
- レビュー
▼ 商品の仕様詳細はこちら

※この商品は受注発注の商品です。その為メーカーに在庫がない場合がございます。
その場合は大変申し訳ございませんがキャンセルとさせて頂きます。予めご了承下さい。
| 特長 |
|
|---|---|
| 用途 |
|
| 仕様 |
|
| 仕様2 |
|
| 材質_仕上 |
|
| 質量 | 19.200KG |
| 原産国 | 日本 |
| JANコード |
|
「ルーペスタジオ」では、拡大鏡(虫眼鏡/ルーペ)、双眼鏡、単眼鏡、望遠鏡などのレンズ製品を主に取り扱っております。工具製品は常には在庫しておらずお取りよせとなります。ご了承下さい。







